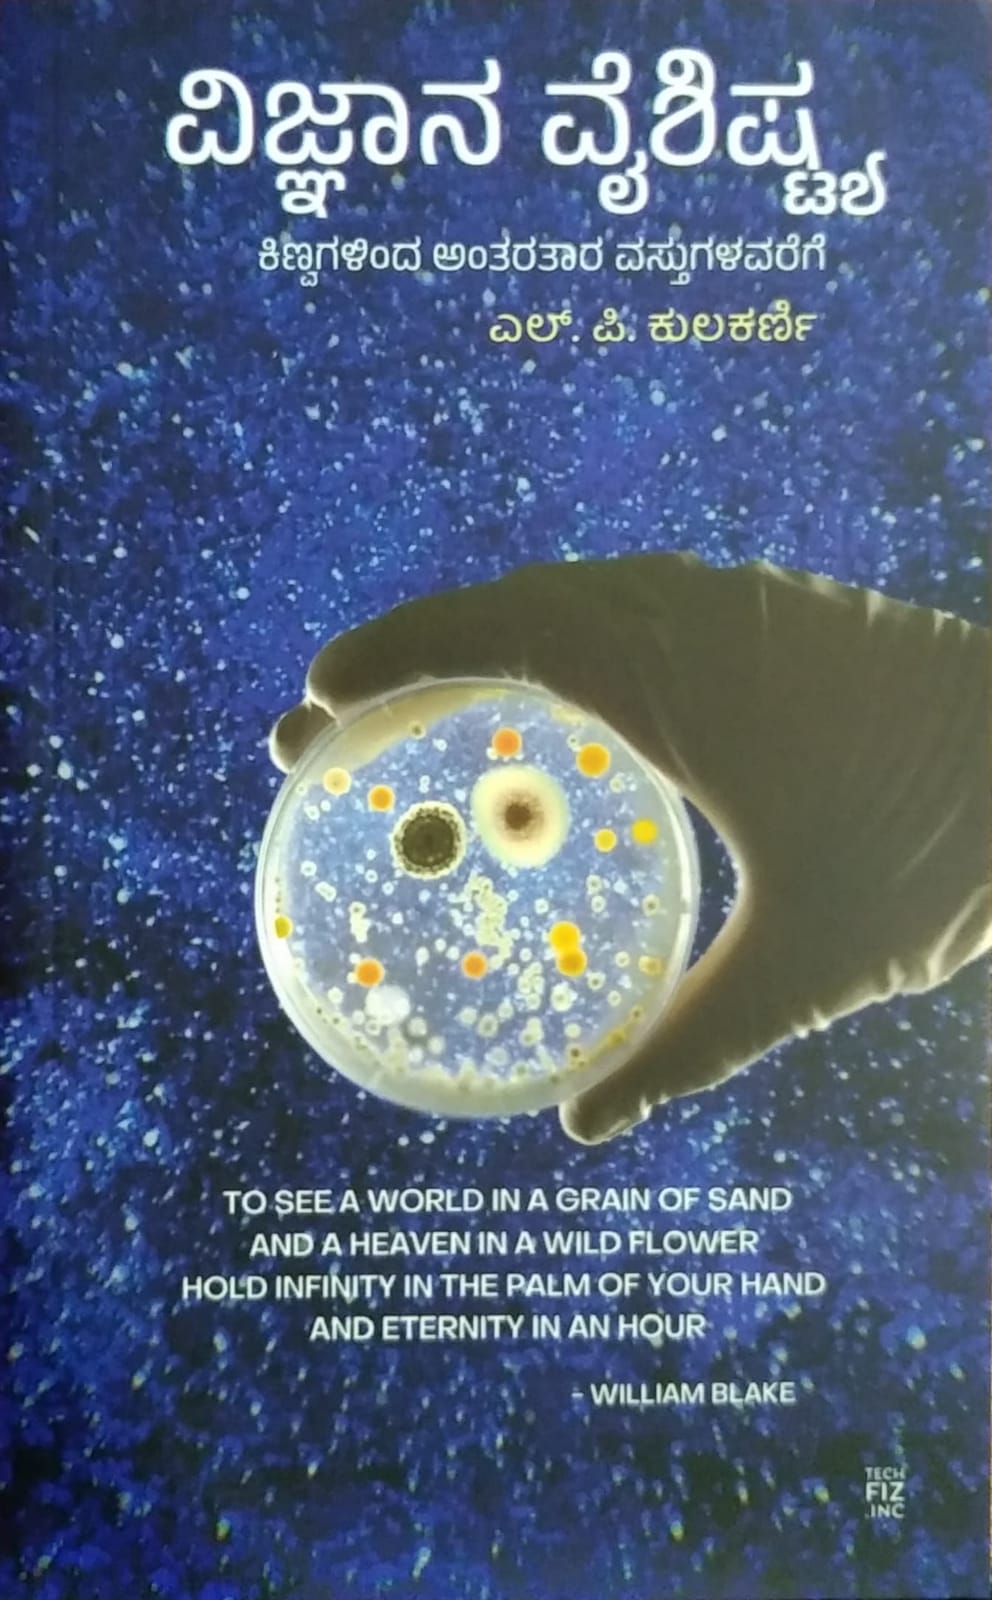

L. P. Kulakarni
ವಿಜ್ಜಾನ ವೈಶಿಷ್ಟ್ಯ
ವಿಜ್ಜಾನ ವೈಶಿಷ್ಟ್ಯ
Publisher -
- Free Shipping Above ₹250
- Cash on Delivery (COD) Available
Pages - 119
Type - Paperback
Couldn't load pickup availability
ಈಚಿನ ವರ್ಷಗಳಲ್ಲಿ ಗಮನಸೆಳೆಯುತ್ತಿರುವ ಕನ್ನಡ ವಿಜ್ಞಾನ ಲೇಖಕರಲ್ಲಿ ಶ್ರೀ ಎಲ್.ಪಿ. ಕುಲಕರ್ಣಿಯವರದ್ದು ಮಹತ್ವದ ಹೆಸರು. ವೃತ್ತಿಯಿಂದ ಶಿಕ್ಷಕರಾಗಿರುವ ಕುಲಕರ್ಣಿ- ಯವರು ತಮ್ಮ ವಿಜ್ಞಾನ ಸಂವಹನದ ಪ್ರವೃತ್ತಿಯಿಂದ ಕನ್ನಡದ ಓದುಗರಿಗೂ ವಿಜ್ಞಾನದ ರುಚಿ ಹತ್ತಿಸುತ್ತಿದ್ದಾರೆ.
ಸದ್ಯ ನಿಮ್ಮ ಕೈಯಲ್ಲಿರುವ ಈ ಕೃತಿ, ಕುಲಕರ್ಣಿಯವರು ವಿವಿಧ ವಿಷಯಗಳನ್ನು ಕುರಿತು ಬರೆದಿರುವ ಲೇಖನಗಳ ಸಂಕಲನ, ವಿಜ್ಞಾನ-ತಂತ್ರಜ್ಞಾನ ಕ್ಷೇತ್ರದ ಹೊಸ ಬೆಳವಣಿಗೆ- ಗಳನ್ನು ಪರಿಚಯಿಸುವುದರ ಜೊತೆಗೆ ಆಯಾ ಬೆಳವಣಿಗೆಗಳ ಹಿಂದಿನ ಪ್ರಾಥಮಿಕ ಪರಿಕಲ್ಪನೆಗಳ ಬಗೆಗೂ ಅವರು ಬರೆದಿದ್ದಾರೆ.
ಈ ಸಂಕಲನದಲ್ಲಿನ ಲೇಖನಗಳು ಮಾಲಿನ್ಯ ಪ್ಲಾಸ್ಟಿಕ್ ಪಿಡುಗು. ಡೋನ್ ತಂತ್ರಜ್ಞಾನ, ಹೊಸಬಗೆಯ ರೋಬಾಟ್ ಗಳು, ಜೀವಜಗತ್ತಿನ ಆಗುಹೋಗುಗಳು ಮುಂತಾದ ಹಲವು ಸಂಗತಿಗಳನ್ನು ಓದುಗರಿಗೆ ಪರಿಚಯಿಸಿವೆ. ನಮಗೆ ಪರಿಚಯವಿರುವ ಸಾಮಾನ್ಯ ವಸ್ತುಗಳಿಂದ ಪ್ರಾರಂಭಿಸಿ ಹಲವು ಸಂಕೀರ್ಣ ವಿಷಯಗಳನ್ನೂ ಸ್ಪರ್ಶಿಸಿವೆ.
ವೈವಿಧ್ಯಮಯ ವಿಷಯಗಳನ್ನು ಕುರಿತ ಈ ಲೇಖನಗಳು ಆಸಕ್ತಿದಾಯಕವಾಗಿರುವುದರ ಜೊತೆಗೆ ವಿಜ್ಞಾನದ ಮುನ್ನಡೆಯನ್ನೂ ದಾಖಲಿಸಿವೆ.ಕುಲಕರ್ಣಿಯವರು ತಮ್ಮಲೇಖನ- ಗಳಲ್ಲಿ ಹಲವೆಡೆ ಇಂಗ್ಲಿಷಿನ ಪದಗಳನ್ನೇ ನೇರವಾಗಿ ಬಳಸಿರುವುದು ಸಂವಹನದ ದೃಷ್ಟಿಯಿಂದಲೂ ಕುತೂಹಲ ಹುಟ್ಟಿಸುವ ಪ್ರಯತ್ನ.
ಕುಲಕರ್ಣಿಯವರ ಸಾಧನೆ ಹೀಗೆಯೇ ಮುಂದುವರೆಯಲಿ, ಕನ್ನಡದ ವಿಜ್ಞಾನ ಸಾಹಿತ್ಯ ಕ್ಷೇತ್ರಕ್ಕೆ ಅವರು ಇನ್ನೂ ಹೆಚ್ಚಿನ ಕೊಡುಗೆ ನೀಡುವಂತಾಗಲಿ ಎನ್ನುವುದು ಅವರ ಓದುಗ- ರೆಲ್ಲರ ಹಾರೈಕೆ. ಹಾಗೆಯೇ, ಅವರ ಸಾಧನೆಯಿಂದ ಪ್ರೇರಿತರಾಗಿ ಇನ್ನೂ ಹಲವಾರು
ಶಿಕ್ಷಕರು ವಿಜ್ಞಾನ ಸಾಹಿತ್ಯದತ್ತ ಮುಖಮಾಡುವಂತಾಗಲಿ!
Share


Best sellers I like your efforts
Subscribe to our emails
Subscribe to our mailing list for insider news, product launches, and more.